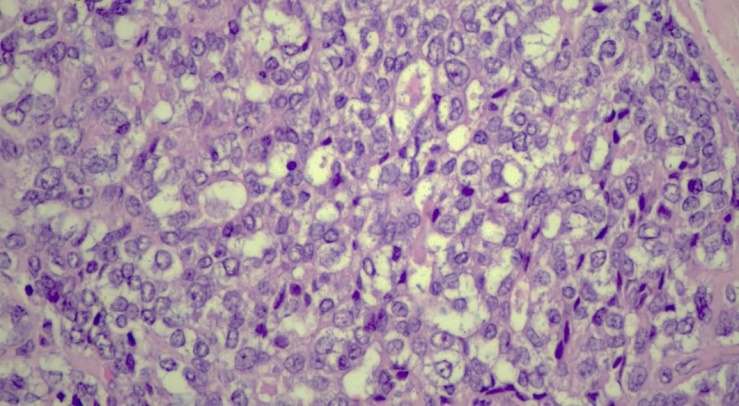
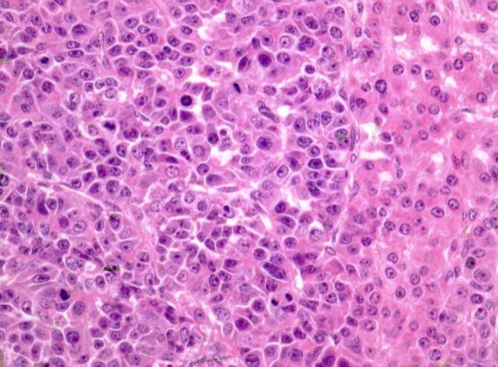

-
Paper Information
- Next Paper
- Previous Paper
- Paper Submission
-
Journal Information
- About This Journal
- Editorial Board
- Current Issue
- Archive
- Author Guidelines
- Contact Us
American Journal of Medicine and Medical Sciences
p-ISSN: 2165-901X e-ISSN: 2165-9036
2026; 16(3): 951-954
doi:10.5923/j.ajmms.20261603.22
Received: Feb. 9, 2026; Accepted: Feb. 27, 2026; Published: Mar. 4, 2026

Hepatoblastoma: Description of the Clinical Case
Ishmuratov F. E.1, Madaliev A. A.2, Karimov A. R.3
1Pathomorphologist, Karakalpakstan branch of the Republican Specialized Scientific and Practical Medical Center of Oncology and Radiology, Uzbekistan
2Head of the Pathomorphology Department of the Republican Specialized Scientific and Practical Medical Center of Oncology and Radiology, Uzbekistan
3Pathomorphologist, Republican Specialized Scientific and Practical Medical Center of Oncology and Radiology, Uzbekistan
Correspondence to: Ishmuratov F. E., Pathomorphologist, Karakalpakstan branch of the Republican Specialized Scientific and Practical Medical Center of Oncology and Radiology, Uzbekistan.
| Email: |  |
Copyright © 2026 The Author(s). Published by Scientific & Academic Publishing.
This work is licensed under the Creative Commons Attribution International License (CC BY).
http://creativecommons.org/licenses/by/4.0/

Hepatoblastoma is the most common malignant liver tumor, most common in early childhood. In the pediatric population, 90% of hepatoblastomas appear before the age of 4 years. It demonstrates significant histological heterogeneity and can be classified as an epithelial or mixed epithelial-mesenchymal subtype. Most cases are sporadic and develop in the liver without previous background liver disease, however, they are sometimes associated with constitutional genetic abnormalities, malformations, and hereditary tumor syndromes such as Beckwith-Wiedemann syndrome and familial adenomatous polyposis. The following is a clinical case of a 4-year-old child who was taken to the hospital with an acute abdomen and bloating.
Keywords: Hepatoblastoma, Pediatric liver tumor, Alpha-fetoprotein (AFP), Epithelial type hepatoblastoma, Embryonal and fetal components, Immunohistochemistry, Liver neoplasms in children, Computed tomography (CECT), Histopathology, Rare childhood malignancy
Cite this paper: Ishmuratov F. E., Madaliev A. A., Karimov A. R., Hepatoblastoma: Description of the Clinical Case, American Journal of Medicine and Medical Sciences, Vol. 16 No. 3, 2026, pp. 951-954. doi: 10.5923/j.ajmms.20261603.22.
1. Introduction
- Hepatoblastoma is a tumor that arises from embryonic parenchymal liver cells, with an annual incidence of 1.2 cases per 1 million people. This disease accounts for about 79% of all liver tumors in children. According to statistics, 90% of all cases of hepatoblastomas occur in children under the age of 4 years [1]. Hepatoblastoma usually has a monofocus character, affecting more often the right lobe of the liver. A slightly higher prevalence is observed among boys. The tumor is divided into epithelial type hepatoblastoma and mixed epithelial/mesenchymal type [2]. Hepatoblastoma is usually manifested by bloating, weight loss and lag in physical development, and may be accompanied by jaundice and fever. At the same time, a high level of alpha-fetoprotein (AFP) in the blood serum is the main diagnostic and prognostic marker. The tumor increases in size quite rapidly, respectively, if the patient is left untreated, he will suffer death as a result of bleeding, liver failure and distant metastases [3]. The following is a description of a clinical case of a 5-year-old child who was taken to the hospital with bloating and abdominal pain. After an X-ray examination, a liver abscess was diagnosed, while histopathology showed that we are actually dealing with a hepatoblastoma.A clinical case. A 4-year-old girl was taken to the emergency department with complaints of an acute stomach and pain in the navel area during the day. Ultrasound examination of the abdominal cavity revealed a heterogeneous tumor-like formation measuring 3.5× 2.3× 2.0 cm. The formation was localized in the VI and VII segments of the liver. A site with calcifications was identified in the tumor lesion. There are separate areas of vascularization on color Dopplerography. Examination using CT with contrast enhancement (CECT) showed a heterogeneous formation without clear boundaries with cavities and outpouring of contrast agent into the VI segment of the liver, as well as hemorrhagic effusion in the abdominal cavity. An urgent laparotomy with tumor resection was performed. Alpha-fetoprotein (AFP) level control showed 55,000 IU/ml.Histopathology. Macroscopic description: a 4.7× 3.1× 2.2 cm fragment of the liver, subcapsularly dissected with a 3.5× 2.3 cm tumor with clear boundaries in the capsule, located directly at the edge of one of the edges of the resection (Fig. 1). The tumor is brownish-white in color with foci of hemorrhages. Microscopic examination shows an encapsulated liver tumor consisting of two lobes. Hepatoblastoma: description of a clinical case. cell types: a) small tumor cells with rounded and oval nuclei, sparse cytoplasm and pronounced nucleoli. These cells were arranged in strands and layers, resembling embryonic liver tissue; b) round and oval cells with a moderate amount of eosinophilic cytoplasm, grouped in the form of trabeculae and chains, similar to fetal liver (Fig. 1,2).
| Figure 1. Hepatoblastoma site with fetal component. Increase .x200. H&E |
 | Figure 2. Hepatoblastoma is a site with an embryonic component. Increase .x200. H&E |
| Figure 3. Epithelial type hepatoblastoma. Fetal "mature" pattern (right side), embryonic "immature" area (left side). Increase .x200. H&E |
2. Discussion
- In children, liver malignancies rank third among all intra-abdominal neoplasms, after adrenal neuroblastoma and Wilms nephroblastoma.The table below presents the results of immunohistochemical analysis for the diagnosis of hepatoblastoma.
 | Table 1 |
3. Conclusions
- Despite a number of achievements in determining the molecular profile and prognosis, there are still many ambiguities and complex issues in the etiopathogenesis of hepatoblastoma. In light of this, it is especially important to combine the efforts of various research teams to further study the pathogenesis of this rare tumor in depth.
 Abstract
Abstract Reference
Reference Full-Text PDF
Full-Text PDF Full-text HTML
Full-text HTML